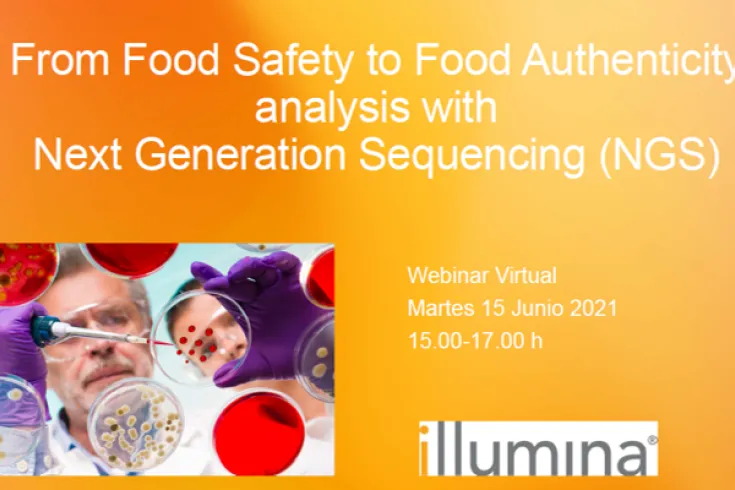
Illumina Webinar

Buscar
Sumario de resultados
TIpos de contenido
Fecha
-
 Noticia
NoticiaORYZON presenta nuevos datos positivos de eficacia del ensayo de iadademstat de Fase IIa ...
Estos datos corresponden a 30 meses de estudio y ofrecen señales robustas de eficacia clínica, con ORR del 83%, de los cuales el 67% son CR/CRi.
-
 Noticia
Noticia#NuevoSocio | "AseBio es, y debe seguir siendo, el elemento aglutinador de la biotecnologí...
Conoce a Nowture, nuestro nuevo socio. Hablamos con Mario Grande, Managing Partner de la empresa
-
-
-
 Oferta de empleo
Oferta de empleoTécnico de Apoyo
-
 Oferta de empleo
Oferta de empleoTécnico
-
 Oferta de empleo
Oferta de empleoPost-doctoral researcher
-
 Oferta de empleo
Oferta de empleoTécnico de Gestión de Proyectos Europeos
-
-
-
 Noticia
NoticiaMedio Ambiente | “Tenemos que ir hacia soluciones biológicas y ahí la biotecnología va a s...
Antonio Molina, director del Centro de Biotecnología y Genómica de Plantas (CBGP, UPM-INIA) y cofundador de Plant Response Biotech, tiene muy claro que solo podremos afrontar los retos climáticos que
-
-
-
 Noticia
Noticia#NuevoSocio | "Asebio nos aporta la red de contactos dentro del ecosistema que facilita nu...
Conoce a Alta Life Sciences, nuestro nuevo socio. Hablamos con Montserrat Vendrell Rius,partner de la compañía
-
 Noticia
NoticiaBiolan Health ha desarrollado “OSAXYL”, solución PoC para el diagnóstico de intolerancia a...
El sistema de medida OSAXYL desarrollado por BIOLAN HEALTH es una herramienta portátil precisa, sencilla y rápida para diagnosticar la hipolactasia
-
-
 Noticia
Noticia¿Es tu software un producto sanitario bajo la MDR e IVDR?
En los últimos años, el software se ha convertido en una herramienta esencial en la tecnología de la salud, revolucionando la atención al paciente
-
-
 Noticia
NoticiaMSD reafirma su apuesta por la investigación poniendo en valor el papel crucial de los ens...
La compañía aspira a convertirse en la principal empresa biofarmacéutica de investigación, a mejorar la salud y el bienestar de las personas y los animales y a ampliar el acceso a sus medicamentos y
-
 Noticia
NoticiaPlasma rico en factores de crecimiento (Endoret® PRGF®) como nuevo tratamiento de fertilid...
Se ha desarrollado un nuevo tratamiento con plasma rico en factores de crecimiento para minimizar los fallos de implantación repetitivos (cuando el óvulo fecundado no se adhiere al endometrio)
-
 Noticia
NoticiaImmunostep desarrolla un nuevo ensayo serológico capaz de diferenciar los anticuerpos gene...
El nuevo test de anticuerpos detecta, con una sola muestra de sangre y con una fiabilidad de más del 99%, tres tipos de anticuerpos contra cuatro proteínas del virus SARS-CoV-2